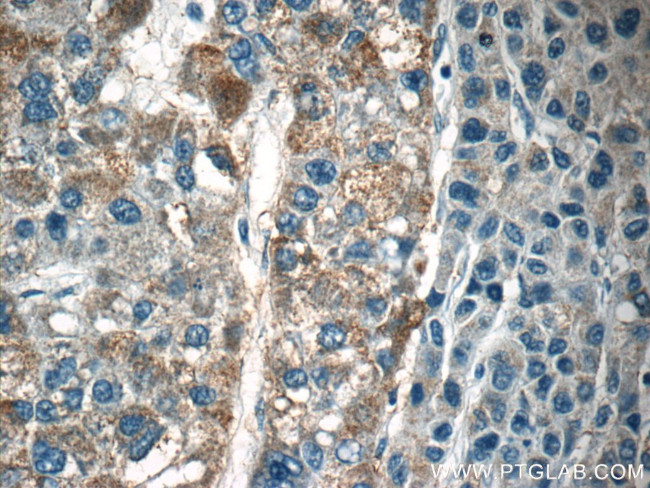
LAPTM4B Antibody in Immunohistochemistry (Paraffin) (IHC (P))

Search
Proteintech
LAPTM4B Polyclonal Antibody
{{$productOrderCtrl.translations['antibody.pdp.commerceCard.promotion.promotions']}}
{{$productOrderCtrl.translations['antibody.pdp.commerceCard.promotion.viewpromo']}}
{{$productOrderCtrl.translations['antibody.pdp.commerceCard.promotion.promocode']}}: {{promo.promoCode}} {{promo.promoTitle}} {{promo.promoDescription}}. {{$productOrderCtrl.translations['antibody.pdp.commerceCard.promotion.learnmore']}}
产品信息
18895-1-AP
种属反应
已发表种属
宿主/亚型
分类
类型
抗原
偶联物
形式
浓度
规格
纯化类型
保存液
内含物
保存条件
运输条件
产品详细信息
This antibody can recognize all the 3 isoforms of LAPTM4B.
Immunogen sequence: TDPAEARSS RGIEEAGPRA HGRAGREPER RRSRQQRRGG LQARRSTLLK TCARARATAP GAMKMVAPWT RFYSNSCCLC CHVRTGTILL GVWYLIINAV VLLILLSALA DPDQYNFSSS ELGGDFEFMD DANMCIAIAI SLLMILICAM ATYGAYKQRA AWIIPFFCYQ IFDFALNMLV AITVLIYPNS IQEYIRQLPP NFPYRDDVMS VNPTCLVLII LLFISIILTF KGYLISCVWN CYRYINGRNS SDVLVYVTSN DTTVLLPPYD DATVNGAAKE PPPPYVSA (84-370 aa encoded by BC014129 )
靶标信息
LAPTM4B is a multi-pass membrane protein. It belongs to the LAPTM4/LAPTM5 transporter family. LAPTM4b has active role in disease progression of malignant cells and is involved in cell proliferation and multidrug resistance. The genetic polymorphism of LAPTM4B is a potential risk factor for the development of colon cancer and gastric cancer. The research results also indicated that LAPTM4B may be a clinically useful prognostic indicator for ovarian carcinoma and may play a role in human hepatocellular carcinoma.
仅用于科研。不用于诊断过程。未经明确授权不得转售。
生物信息学
蛋白别名: LAPTM4B; LAPTM4B_v1; LAPTM4B_v2; LAPTM4beta; lysosomal associated protein transmembrane 4 beta; lysosomal-associated protein transmembrane 4B; lysosomal-associated transmembrane protein 4; Lysosomal-associated transmembrane protein 4B; Lysosome-associated transmembrane protein 4-beta; unnamed protein product
基因别名: C330023P13Rik; LAPTM4B; LAPTM4beta; LC27; PSEC0001
UniProt ID: (Human) Q86VI4, (Rat) Q5U1W4, (Mouse) Q91XQ6
Entrez Gene ID: (Human) 55353, (Rat) 315047, (Mouse) 114128